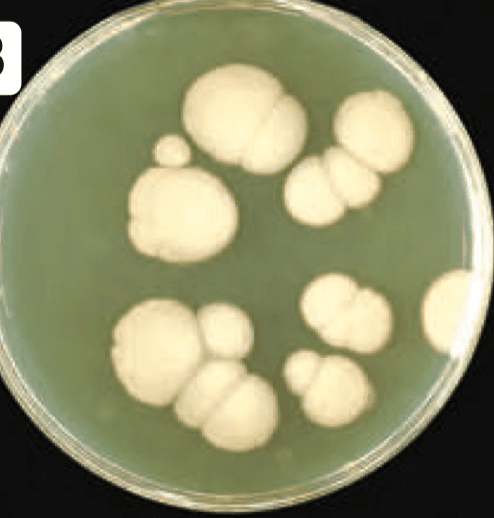
Question Image

Micología
Quiz by Karina Sm
Feel free to use or edit a copy
includes Teacher and Student dashboards
Measure skillsfrom any curriculum
Measure skills
from any curriculum
Tag the questions with any skills you have. Your dashboard will track each student's mastery of each skill.
With a free account, teachers can
- edit the questions
- save a copy for later
- start a class game
- automatically assign follow-up activities based on students’ scores
- assign as homework
- share a link with colleagues
- print as a bubble sheet
40 questions
Show answers
- Q1Paciente femenino de 20 años de edad, acude a revisión médica por presentar prurito y dolor urente en vulva y zona vaginal. Se encuentra descarga vaginal blanquecina grumosa no fétida. Se realiza cultivo en agar Sabouraud con crecimiento de colonias (ver imagen). La paciente también refiere haber terminado esquema de antibiótico por infección de vías respiratorias reciente. Menciona la patología y el agente causal más probable.Tricomoniasis por Trichomonas vaginalisVaginosis bacteriana por Gardnerella vaginalisCandidiasis vaginal por Candida Albicans.Candidiasis vaginal por Candida vaginalis120s
- Q2¿A cuál reino pertenecen los hongos?AnimaliaProtistaMóneraFungi60s
- Q3Hongo dismórfico que se encuentra comúnmente en el suelo húmedo en zonas templadas, cuevas y edificios viejos, asociado a nidos de murciélagos y aves.Paracoccidiodes BrasiliensisBlastomyces DermatitidisHistoplasma CapsulatumCryptococcus Neoformans60s
- Q4¿Cuál es el principal mecanismo de transmisión de la Histoplasmosis?Inhalación de esporasContacto directo con personas infectadasFecal-oralHematógena60s
- Q5Enfermedad caracterizada por presencia de Blastoconidias de diferentes tamaños al examen directo con KOH al 10% con forma de "timón de barco". (Ver imagen)CriptococosisParacoccidioidomicosisCoccidioidomicosisAspergilosis120s
- Q6Agente causal de micosis superficial que se presenta clínicamente con lesiones en piel hipo o hipercrómicas cubiertas de descamación fina (Ver imagen) en tronco, espalda, cuello y hombros, con fluorescencia dorada/amarilla bajo la Luz de Wood. Se caracteriza por imagen en "albóndigas y espagueti" en el examen directo con KOH al 10%.Trichophyton rubrumMicrosporum sp.Malassezia furfurTrichophyton tonsuran120s
- Q7Acude a consulta paciente femenino de 33 años de edad, con antecedente de transplante hepático hace 2 meses, hace 2 días regresó de Arizona en donde estuvo una semana. Inició hace 2 días con fiebre de 38ºC, tos seca, disnea de medianos esfuerzos, astenia y adinamia. Se realiza Rx de tórax encontrando patrón micronodular bilateral. ¿Cuál es el diagnóstico más probable y su agente causal?Blastomicosis por B. dermatitidisAspergilosis por A. fumigatusCoccidioidomicosis por C. ImmitisNeumonía adquirida en la comunidad por S. Pneumoniae120s
- Q8¿Qué órganos/tejidos pueden verse afectados por Coccidioidomicosis?Todas las opciones son correctasMeninges y PielPulmón y HuesoSistema Nervioso Central y Articulaciones60s
- Q9Acude una paciente de 65 años con antecedente de Diabetes Mellitus tipo 2, refiere una sensación “rara” en la boca que le molesta desde hace una semana, además ha observado la presencia de unas placas blancas en la lengua, que a pesar de lavarse la boca y la lengua no desaparecen. ¿Cuál es la sospecha diagnóstica en ésta paciente?Leucoplasia VellosaLiquen PlanoCandidiasis orofaríngeaCandidiasis Invasiva60s
- Q10El siguiente agente causal produce Meningitis subaguda en pacientes inmunodeprimidos. Se diagnostica mediante visualización de estructuras típicas por tinción de tinta china en LCR (líquido cefalorraquídeo) con imagen en "huevos fritos". (Ver imagen).Coccidioides ImmitisNeumococoMycobacterium aviumCryptococcus Neoformans60s
- Q11La infección por Cryptococcus neoformans se da mediante la inhalación de esporas, principalmente asociadas a las deposiciones de palomas, pichones y gallinas.FalsoVerdadero60s
- Q12¿Cual de las siguientes es una prueba específica para el diagnóstico de Aspergilosis?Gammagrafía pulmonarDeterminación en sangre de GalactomananoRadiografía de tórax posteroanterior y lateralTAC de tórax60s
- Q13Agente causal principal de la Tiña de la cabeza en humanos.Epidermophyton floccosumTrichophyton tonsuransTrichophyton rubrumCandida Albicans60s
- Q14Paciente masculino de 62 años de edad, quien padece Diabetes Mellitus tipo 2 de larga evolución, acude a su consultorio por presentar desde hace 1 mes engrosamiento de uñas de miembros inferiores, con cambios en coloración e hiperqueratosis subungueal. (Ver imagen). A la exploración física se confirma el diagnóstico de ______(1)______. Por lo cual se decide tratar con ______(2)_________.1. Tiña pedis 2. Fluconazol1. Onicomicosis 2. Terbinafina1. Tiña de uñas 2. Anfotericina B1. Tiña corporis 2. Itraconazol crema60s
- Q15Los siguientes son factores de riesgo para adquirir la Tiña de uñas:Uso de AINEs prolongado, tabaquismo.Exposición en albercas y baños públicos, inmunocompromiso, clima tropical.Edad >65 años, trabajar en el campo, zoonosis.Sexo femenino, infección respiratoria reciente, embarazo.60s